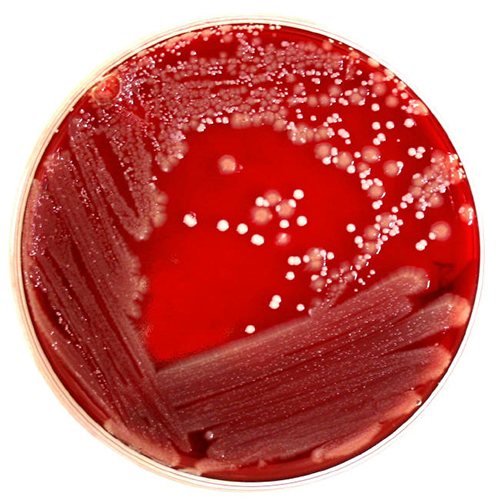
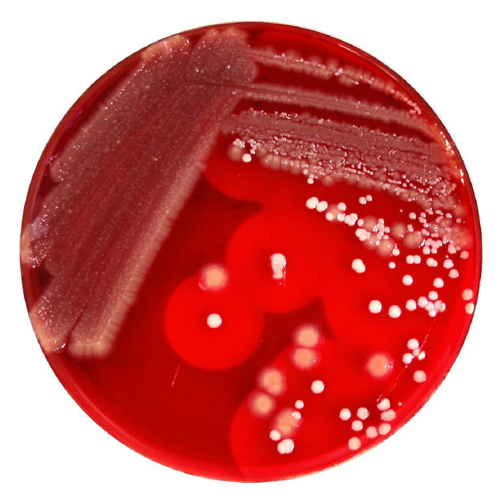
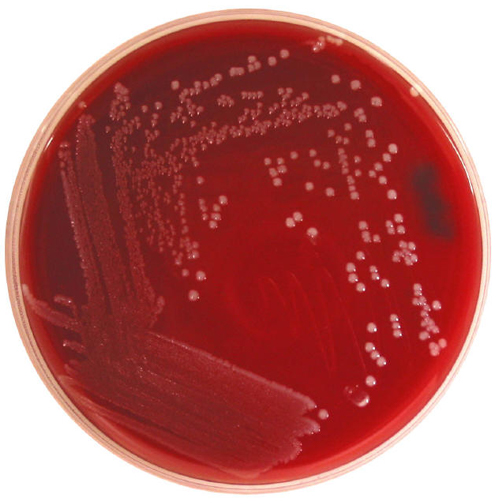
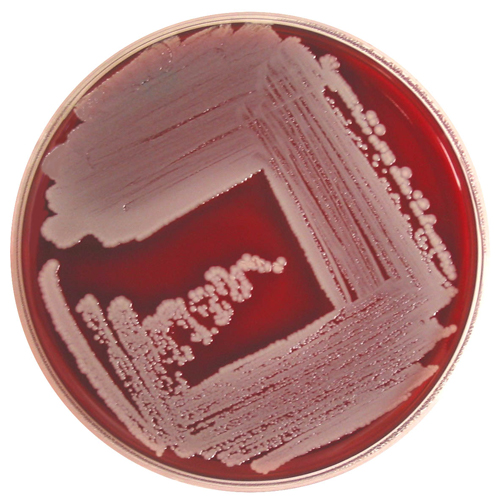

Streak Plate Examples
Click on the thumbnails below to view the full sized images

4 quadrant streak technique
This is an image of a 4 quadrant streak technique.
Quad 1 is takes up about 1/4 to 1/3 of the plate.
Quad 2 goes into quad 1 two to three times and then feathers out to a point. Quad 2 is the major quad on the plate.
Quad 3 is exactly the same as quad 2, going into the previous quad two to three times and then feathering out to a point near quad 1.
Quad 4 starts at the base of quad 3 and moves out to the center of the plate filling what ever space is left over.